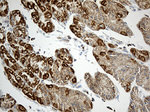
ACADM Antibody in Immunohistochemistry (Paraffin) (IHC (P))
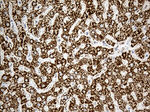
ACADM Antibody in Immunohistochemistry (Paraffin) (IHC (P))

Search
OriGene
ACADM Monoclonal Antibody (OTI10A5), TrueMAB™
{{$productOrderCtrl.translations['antibody.pdp.commerceCard.promotion.promotions']}}
{{$productOrderCtrl.translations['antibody.pdp.commerceCard.promotion.viewpromo']}}
{{$productOrderCtrl.translations['antibody.pdp.commerceCard.promotion.promocode']}}: {{promo.promoCode}} {{promo.promoTitle}} {{promo.promoDescription}}. {{$productOrderCtrl.translations['antibody.pdp.commerceCard.promotion.learnmore']}}
产品信息
TA811764
种属反应
宿主/亚型
分类
类型
克隆号
抗原
偶联物
形式
浓度
纯化类型
保存液
内含物
保存条件
运输条件
靶标信息
This gene encodes the medium-chain specific (C4 to C12 straight chain) acyl-Coenzyme A dehydrogenase. The homotetramer enzyme catalyzes the initial step of the mitochondrial fatty acid beta-oxidation pathway. Defects in this gene cause medium-chain acyl-CoA dehydrogenase deficiency, a disease characterized by hepatic dysfunction, fasting hypoglycemia, and encephalopathy, which can result in infantile death. Alternatively spliced transcript variants encoding different isoforms have been found for this gene.
仅用于科研。不用于诊断过程。未经明确授权不得转售。
篇参考文献 (0)
生物信息学
蛋白别名: acyl-CoA dehydrogenase C-4 to C-12 straight chain; acyl-Coenzyme A dehydrogenase, C-4 to C-12 straight chain; FLJ18227; FLJ93013; FLJ99884; MCAD; MCADH; Medium chain acyl-CoA dehydrogenase; Medium-chain specific acyl-CoA dehydrogenase, mitochondrial; RP4-682C21.1; testicular tissue protein Li 7
基因别名: ACAD1; ACADM; MCAD; MCADH
UniProt ID: (Human) P11310
Entrez Gene ID: (Human) 34